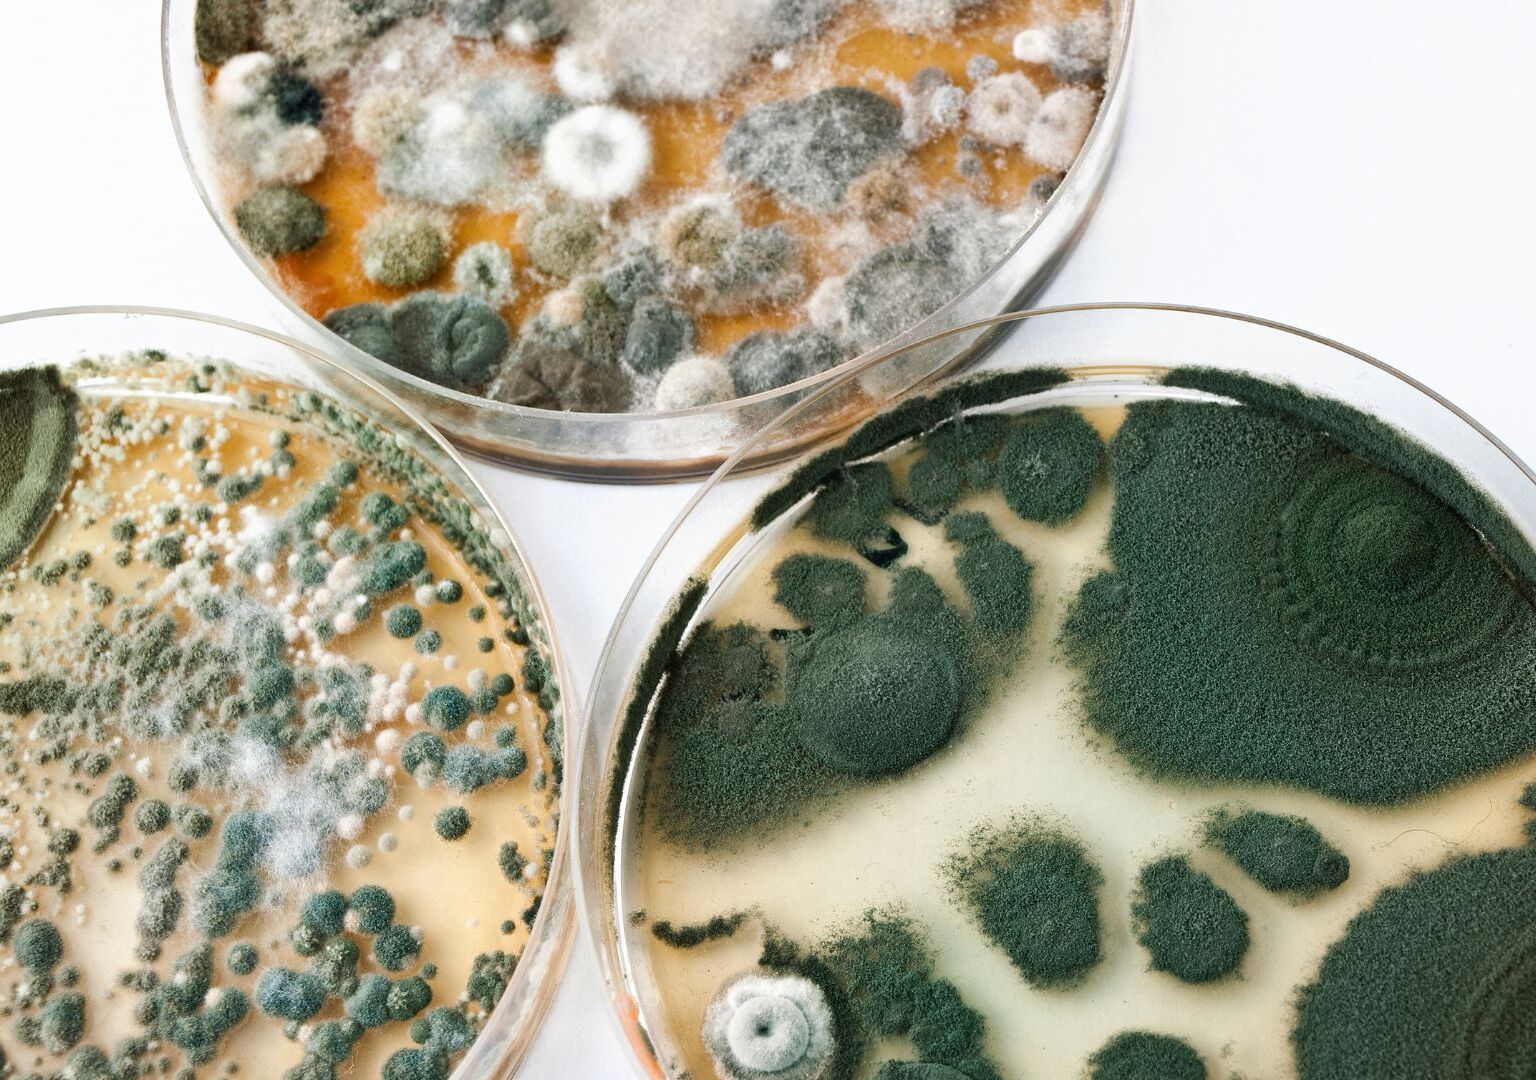
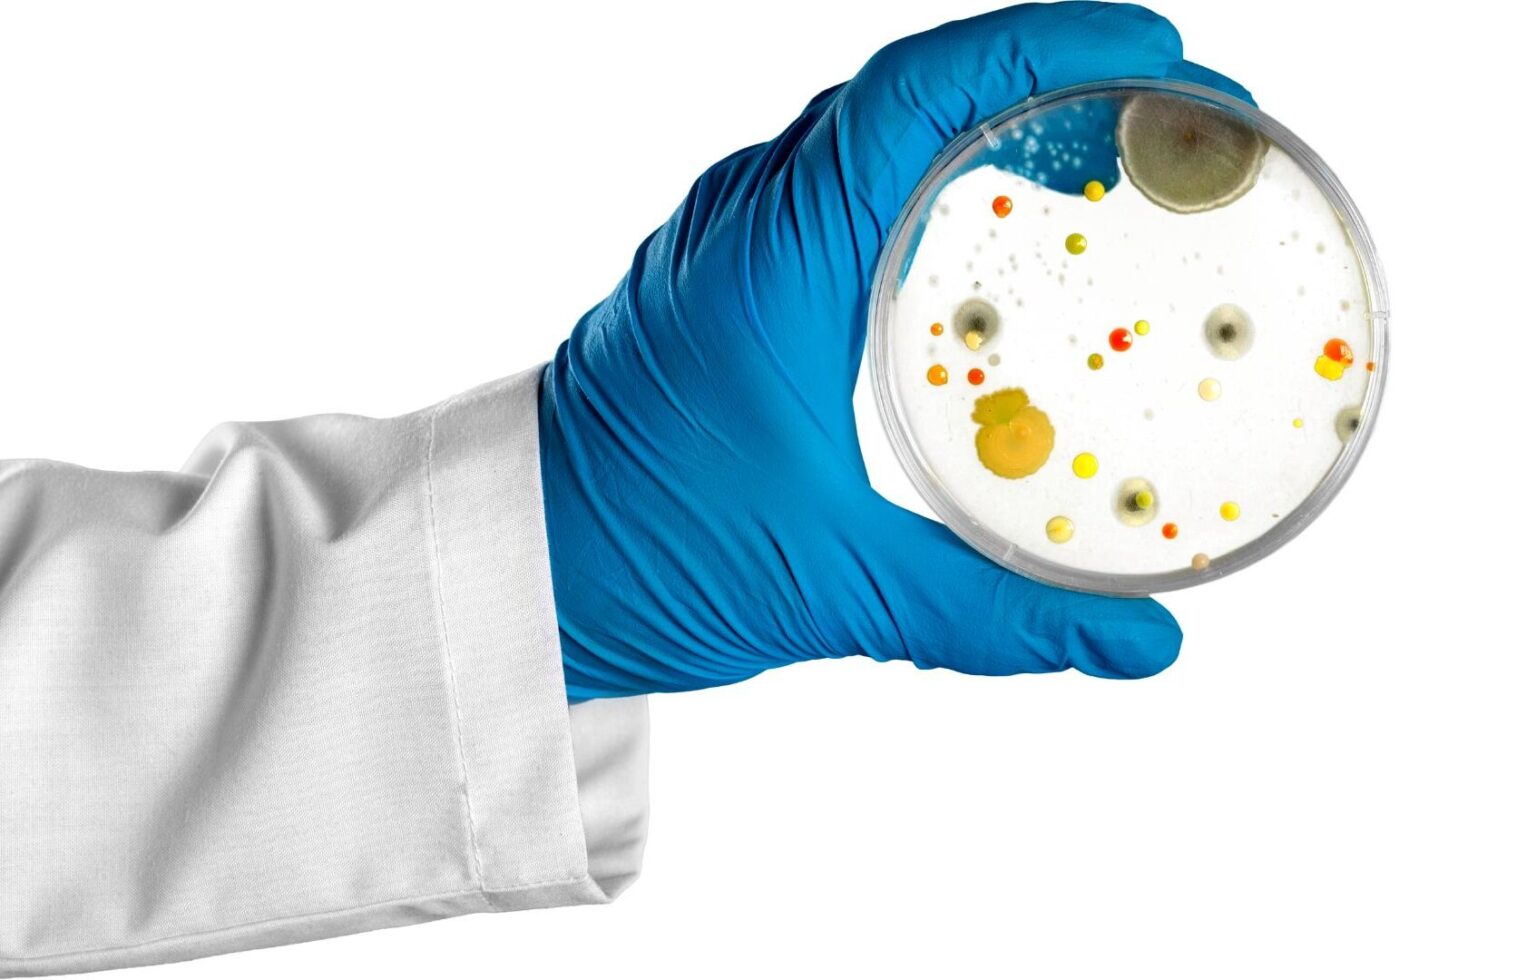
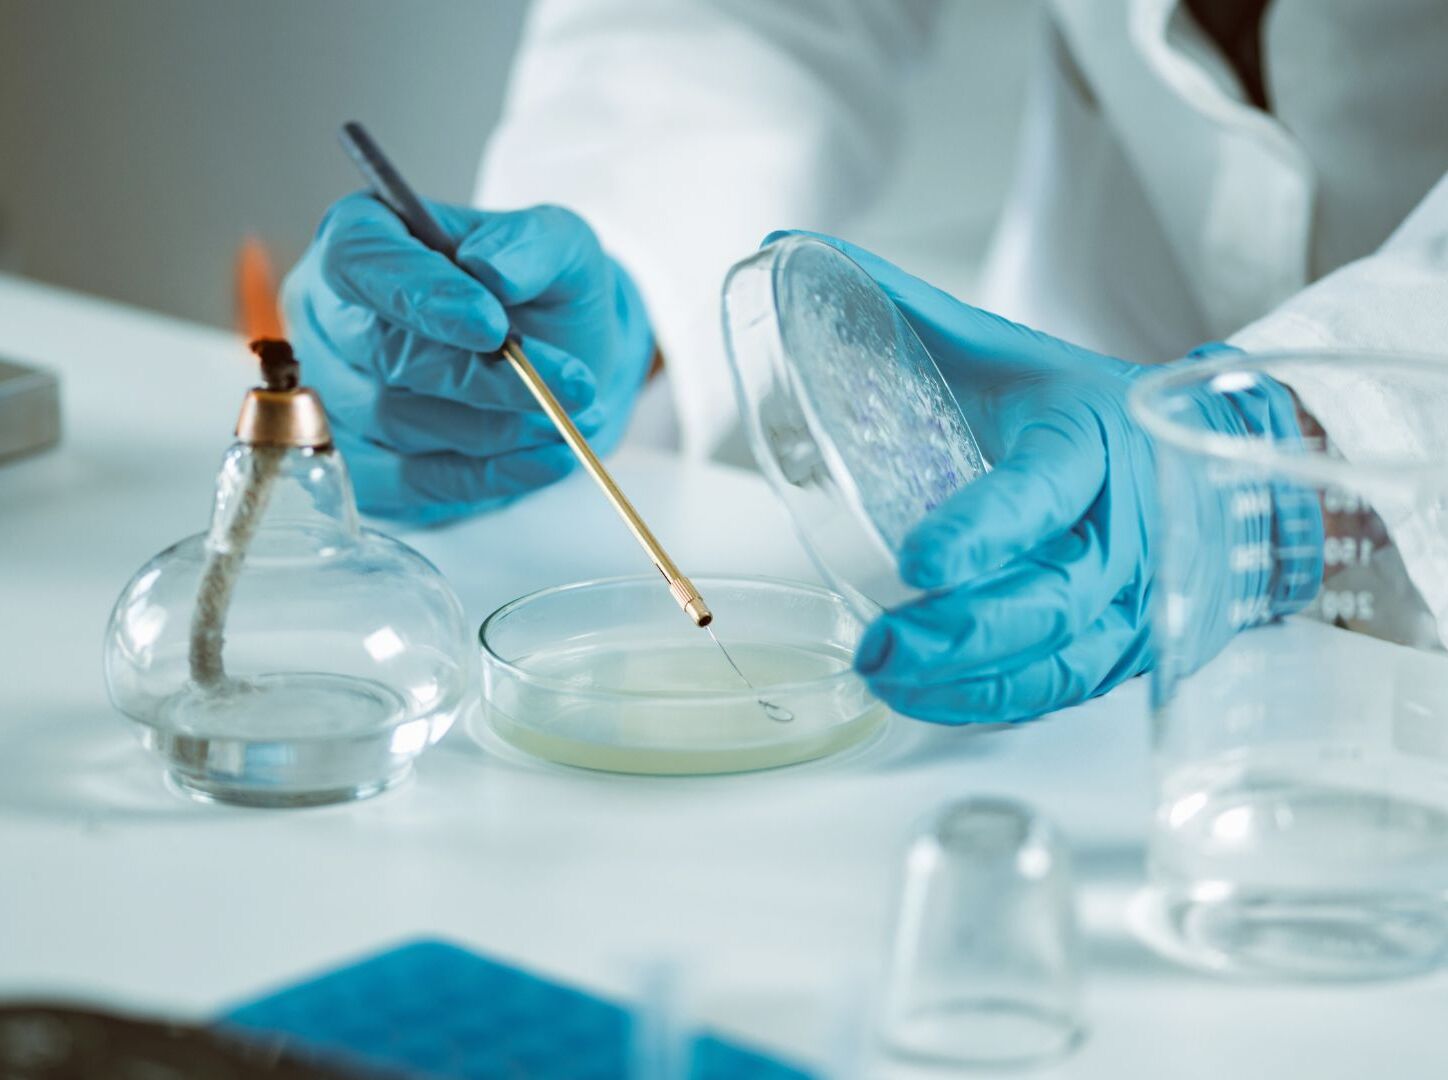
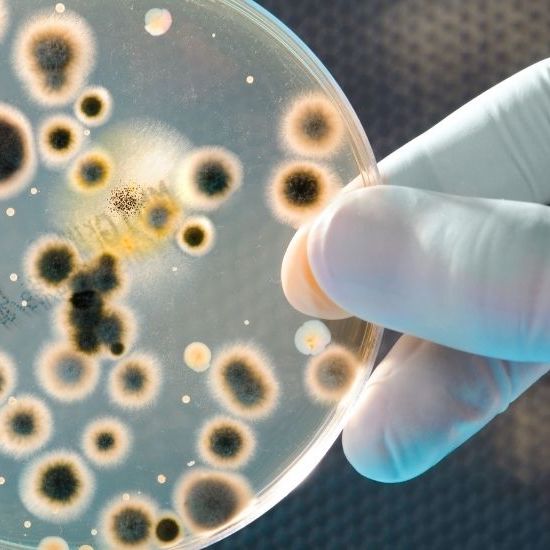
Porque a resistencia microbiana e uma ameaca mundial site

Fortalecemos la investigación, brindando servicios a todo tipo de instituciones públicas y privadas sobre recursos biológicos, tanto en la Universidad, la región y el país. Para solicitar servicios, análisis y uso de equipamiento puede escribirnos directamente e indicar su requerimiento vía mail a pablo.demanet@ufrontera.cl cc a bioren@ufrontera.cl.